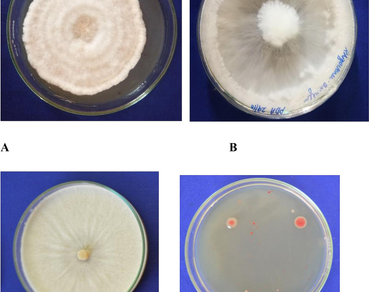
Rhizome rot, Molecular characterization, Pathogen complex

Elucidating the molecular profile of pathogens inducing rhizome rot in ginger (Zingiber officinale Rosc.)
Research Articles | Published: 21 June, 2024
First Page: 2018
Last Page: 2025
Views: 2577
Keywords: Rhizome rot, Molecular characterization, Pathogen complex
Abstract
Rhizome rot is the leading debilitating disease affecting ginger, prevalent in various regions of India where the crop is cultivated. This term refers to all diseases impacting the rhizome, regardless of the pathogens involved, as they ultimately result in partial or total rhizome loss. The disease arises from the interaction of multiple pathogens, creating a complex scenario that complicates management strategies. The specific pathogens involved influence both the nature of the damage and the symptoms exhibited. The present study carried out to understand the complex nature of the disease and pathogens involved in the disease development. Molecular characterization identified the causative organisms at the species level, including Pythium aphanidermatum, Fusarium oxysporum, Fusarium solani, Sclerotium rolfsii, Ralstonia solanacearum, Meloidogyne hapla, and Meloidogyne enterolobii.
References
Aravind S, Chaithanya KC, Sivaranjani R, Kandiannan K, Srinivasan V, Sankar SM, Babu KN (2024) Induction of in vitro micro rhizomes and assessment of yield, quality, and clonal fidelity in ex vitro established plants of ginger (Zingiber officinale Rosc). Plant Cell Tissue Organ Cult (PCTOC) 157(2):1–13
Archana TS, Mesta RK, Basavarajappa MP, Kumar KCK (2023) Promoting resilience in ginger: Elicitor-driven strategies to combat the rhizome rot disease. J Phytopathol 171(11–12):627–641
Ariute JC, Felice AG, Soares S, da Gama MAS, de Souza EB, Azevedo V, Benko-Iseppon AM (2023) Characterization and association of Rips repertoire to host range of novel Ralstonia solanacearum strains by in silico approaches. Microorganisms 11(4):954
Bahar M, Shahab H (2011) Analysis of Iranian isolates of Fusarium solani using morphological, pathogenicity and microsatellite DNA marker characterization. Afr J Biotechnol 11(2):474–482
Bhardwaj RL, Mukherjee S (2011) Effects of fruit juice blending ratios on kinnow juice preservation at ambient storage condition. Afr J Food Sci 5(5):281–286
Chauhan HL, Patel MH (1990) Etiology of complex rhizome rot of ginger (Zingiber officinale) in Gujarat and in vitro screening of fungicides against its causal agents. Indian J Agric Sci 60(1):80–81
Chebte A (2015) Genetic diversity of Fusarium isolates from onion basal rot and their inhibition by antagonistic Bacillus isolates under laboratory and glasshouse conditions. M.Sc Thesis, Addis Ababa University
Elliott SM (2003) Rhizome rot disease of ginger. Crop and Plant Protection Unit, Ministry of Agriculture, Bodies Research Station, sent. Catherina, Jamaica, West Indies
Islam MM, Khatun F, Faruk MI, Rahman MM, Hossain MA (2019) Incidence of rhizome rot of ginger in some selected areas of Bangladesh and the causal pathogens associated with the disease. Bangladesh J Agricultural Res 44(3):569–576
Jan S, Khan TA (2002) Interactive effect of Fusarium solani, Rotylenchulus reniformis and Meloidogyne javanica on tomato. Indian J Nematology 32(2):135–138
Kannahi M, Dhivya U, Kumar RS (2016) Biocontrol efficacy of Trichoderma spp. against rhizome rot disease of Zingiber officinale Rosc. Int J Pharm Sci Rev Res 36(1):63–66
Kaushal N, Sharma N, Sharma P (2023) An innovative approach for biocontrol of Meloidogyne incognita in ginger using potential bacteria isolated from Indian Himalayas. Curr Microbiol 80(12):381
Kifelew H, Kassa B, Sadessa K, Hunduma T (2015) Prevalence of bacterial wilt of ginger (Zingiber officinale) caused by Ralstonia solanacearum (Smith) in Ethiopia. Int J Res Stud Agricultural Sci 1:14–22
Sharma V, Thakur M, Chauhan A (2024) Isolation, identification, pathogenicity test and molecular characterization of Fusarium oxysporum f. sp. zingiberi causing Fusarium yellows disease from infected rhizomes of ginger (Zingiber officinale Rosc). J Plant Pathol, 1–6
Silué NS, Kouamé AEP, Séka K, Cissé N (2023) Assessment of the pathogenicity of fungi associated with ginger (Zingiber officinale) cultivated in two production areas in Côte d’Ivoire. Journal of Phytopathology
Subedi N, Cowell T, Cope-Arguello M, Paul P, Cellier G, Bkayrat H, Miller SA (2024) Characterization of Ralstonia pseudosolanacearum diversity and screening tomato, pepper, and eggplant resistance to manage bacterial wilt in South Asia. PhytoFrontiers™, pp PHYTOFR–10
Sui Y, Huang K, Sun X, Li Y, Xu P, Li N, Pang M (2024) The potential pathogenic fungus of ginger (Zingiber officinale) wilt disease: Fusarium spp. Journal of Plant Pathology
Mahadevakumar, S., Yadav, V., Tejaswini, G.S. & Janardhana, G.R. (2016). Morphological and molecular characterization of Sclerotium rolfsii associated with fruit rot of Cucurbita maxima. European Journal of Plant Pathology, 145(1), 215-219.
Author Information
Department of Plant Pathology, University of Horticultural Sciences, Bagalkot, India